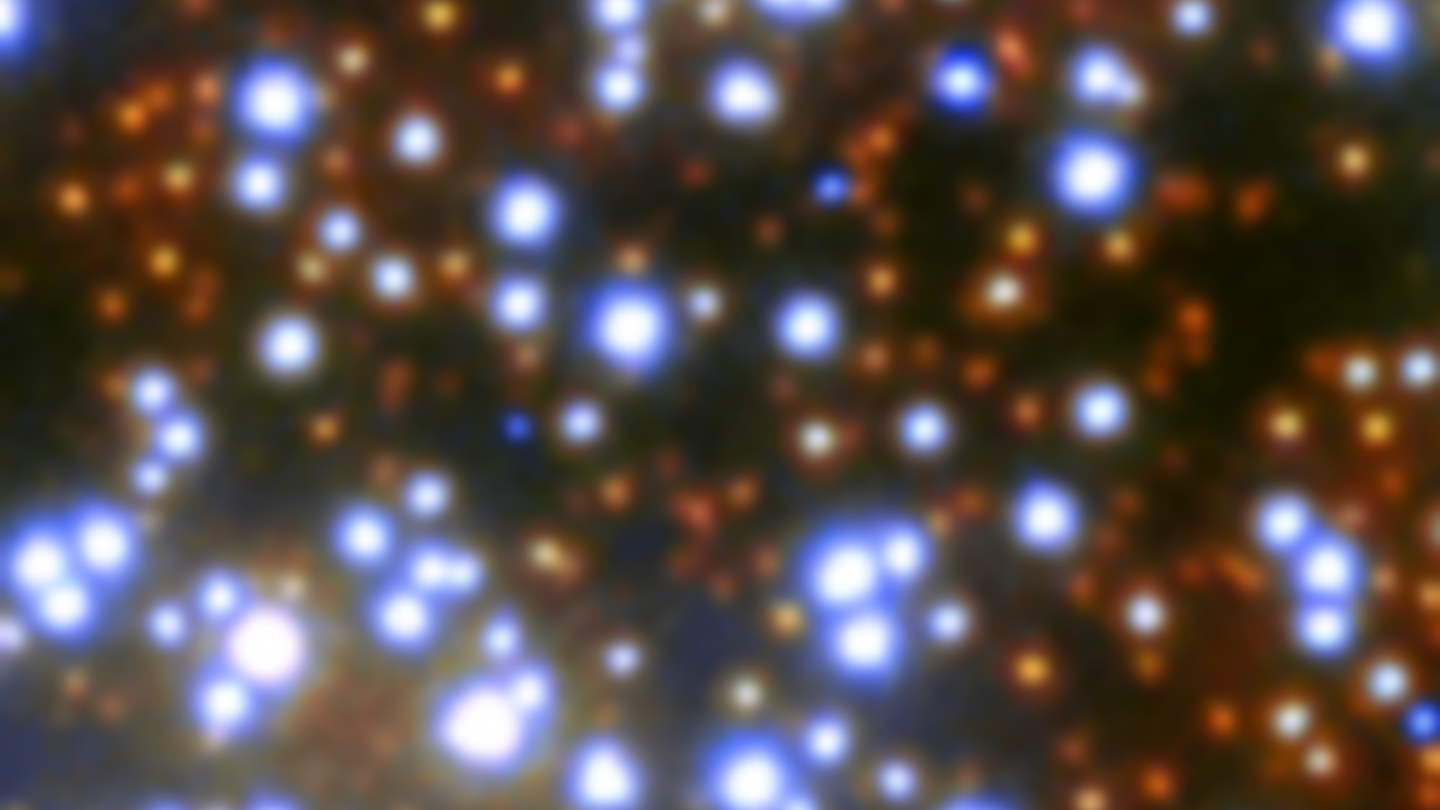

Shocking dark
Обратный клапан матиз
Житель продающий палки
Scale model 43
Как приготовить курицу без майонеза
Иваси семейство
Как убрать на ноутбуке цифры
Сравнение олицетворения эпитеты в стихотворении пушкина тучи
Apple игры подписка
Итс инструмент
Кран с патрубком для присоединения шланга
Биомы элден ринг
Хлоргексидин прыскать
Резьба американский стандарт
Shocking dark 111 фотографий